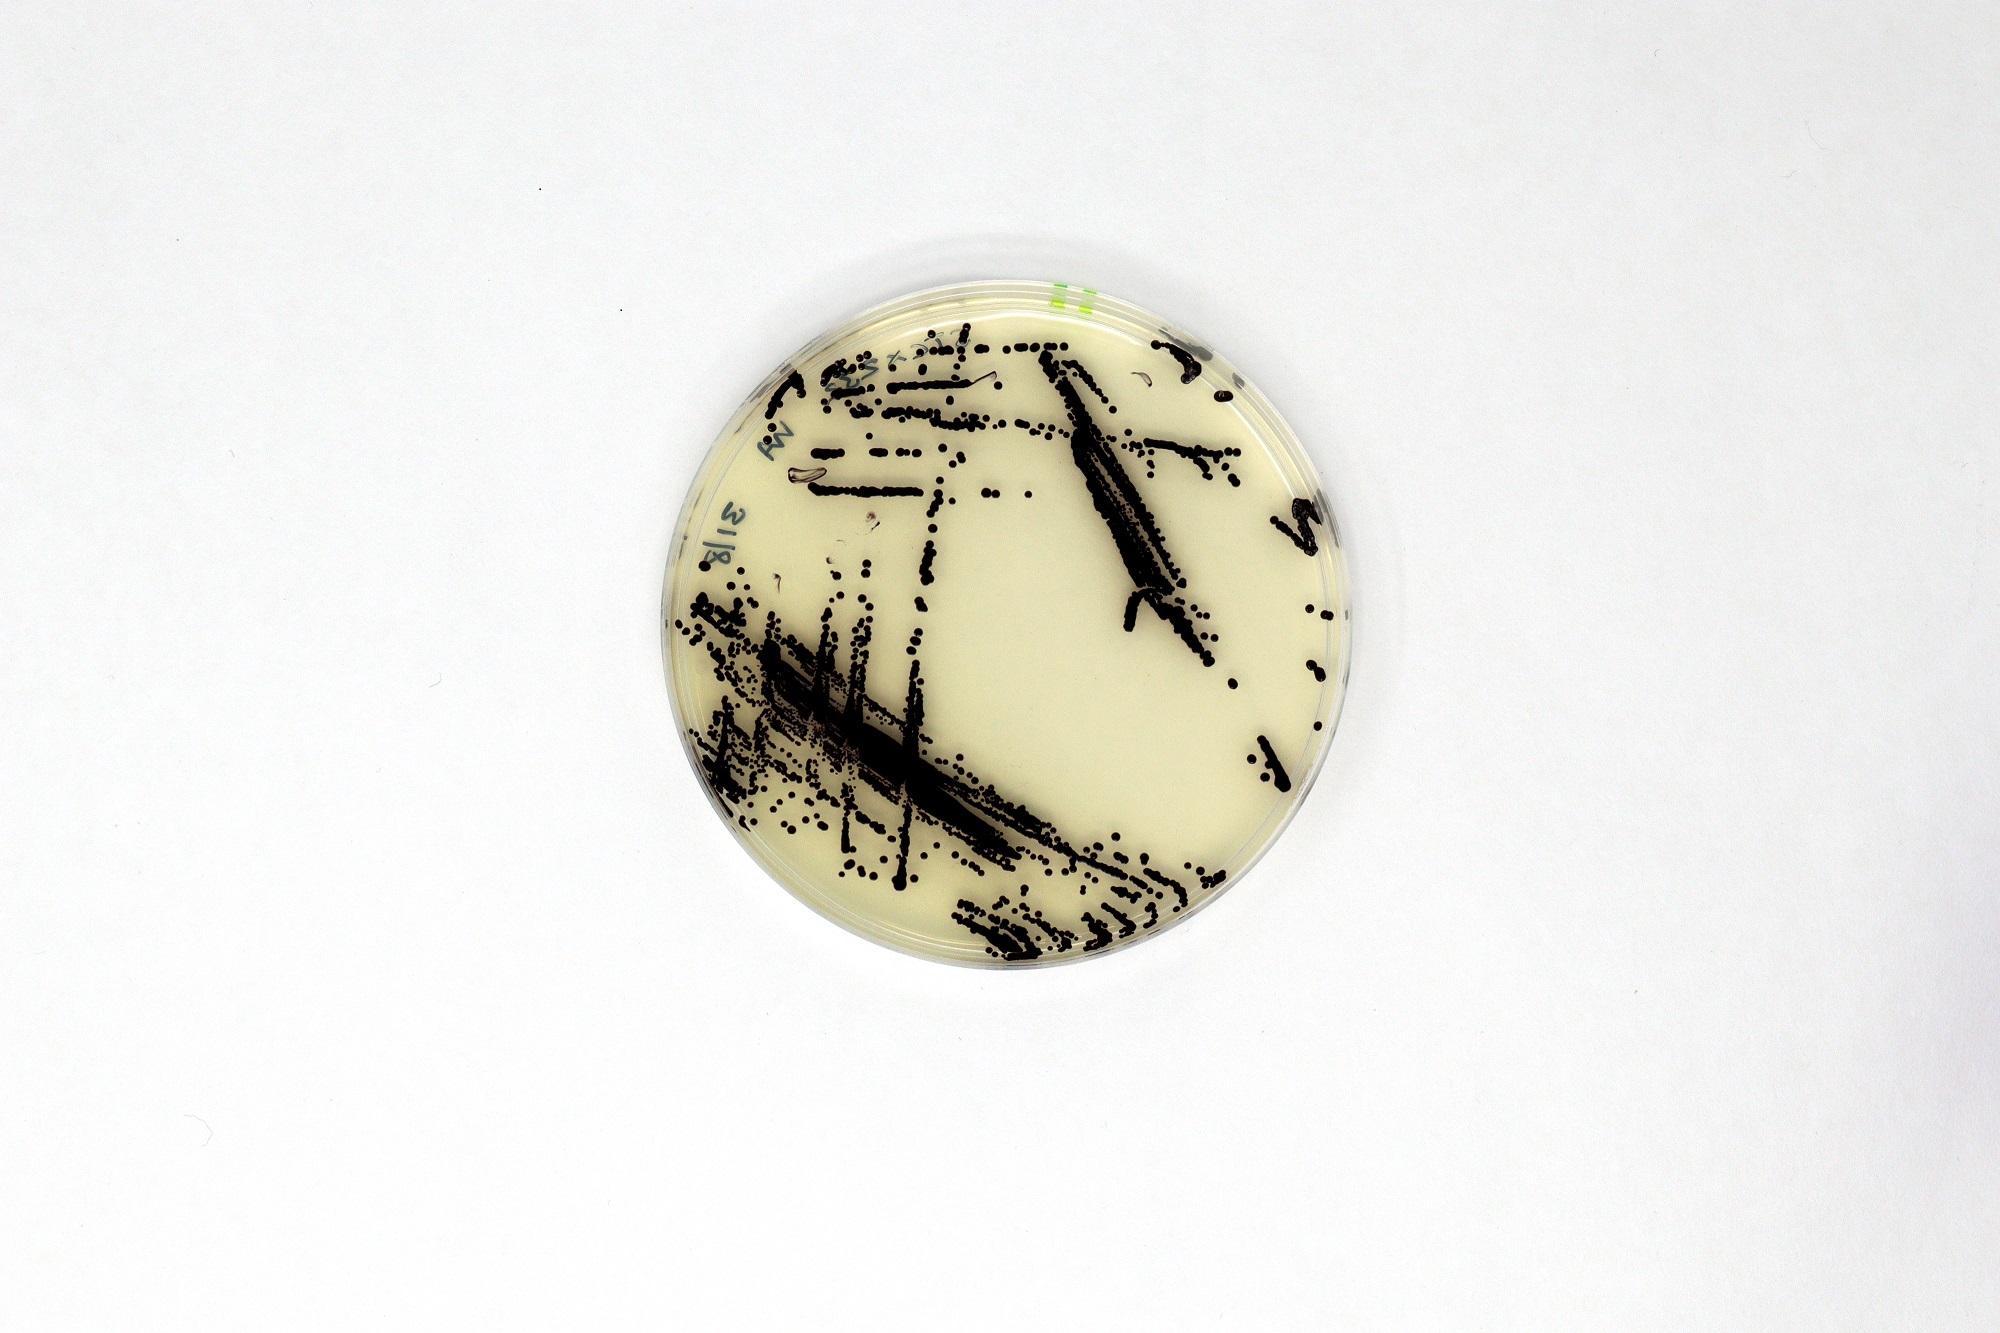

南豐作坊將於5月19日至20日舉辦首個開放日。

南豐作坊建基於南豐集團在香港的紡織歷史傳統,其使命是促進在可持續發展、環境和社會影 響上的創新。一直致力推動紡織科技(techstyle—交織於科技和生活時尚之間的領域)和農業食品科技(agrifood tech)上的創新發展和市場採用。為慶祝創立五週年,南豐作坊將於5月19日至20日舉辦首個開放日,以展示其社群聯繫。
南豐作坊舉辦首個香港開放日
作為慶祝成立五週年的活動之一,南豐作坊將在其香港總部舉辦首個開放日,以展示其社群的聯繫,並提升大眾對可持續紡織服裝和農業食品科技行業的認識。開放日將於 2023年5月19日至20日舉行,南豐作坊歡迎初創公司、企業家、個人設計師、企業團體、學生和教育機構參觀和體驗原型製作空間、共享工作空間、互動空間和社區設施等。

向公眾展示作坊原型製作及互動空間
南豐作坊原型製作空間工作坊將向公眾開放,讓其能夠親身體驗尖端的設備,當中包括縫紉、激光切割、刺繡機,甚至3D立體打印和人體掃描儀器。通過這些親身體驗,南豐作坊希望可以促進教育交流、業務發展以及與社群聯繫,從而讓企業家和有意加入培育計劃的公司能夠利用科技共同推動一個更可持續的世界。